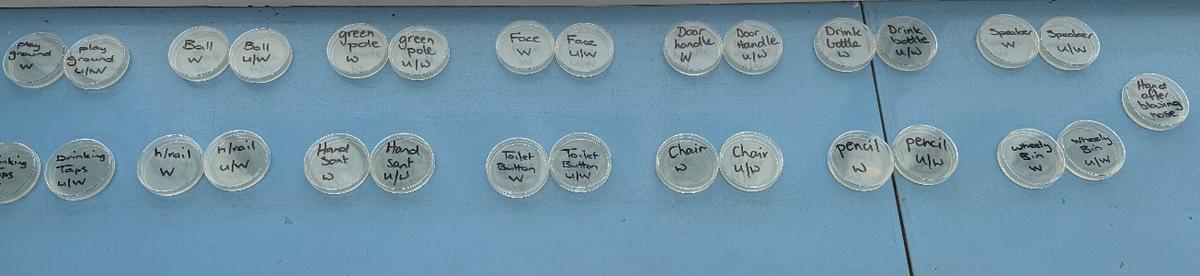
Gallery Image

Kitchen Garden Snr

🥕 Kitchen Garden News 🧑🍳🌱
Our Kitchen Garden program has been full of hands-on learning, curiosity, and excitement!
Over the past few weeks, students have been focusing on food safety and correct food handling practices. We have discussed why it is important to wash our hands before cooking, and how to keep our cooking spaces clean and hygienic.
To deepen their understanding of hygiene, students also took part in a fun and fascinating science experiment about germs and bacteria. In pairs, both students touched the same object. One student then washed their hands carefully while singing “Happy Birthday” (to ensure they washed for long enough!), while the other student did not wash their hands.
After this, both students had their hands gently swabbed. The samples were scratched onto petri dishes and set aside so they can observe what grows over time. The students were incredibly excited and extremely curious about what might appear on their dishes! There were lots of predictions, thoughtful discussions, and wide eyes as we talked about invisible germs and how easily they can spread.
Student are looking forward to observing the results together and continuing to build their knowledge about staying safe and healthy in the kitchen!